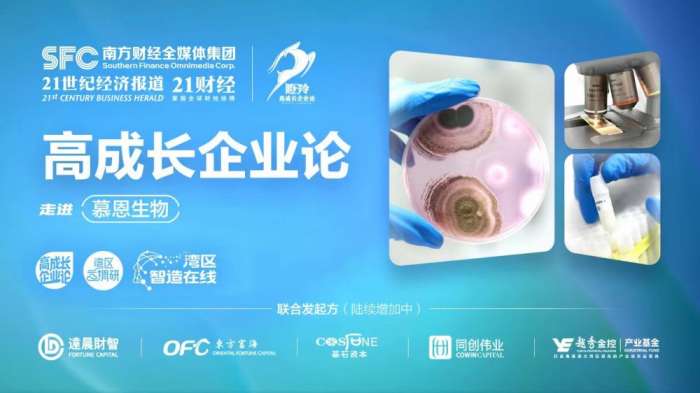

高成长企业论 | 这家企业为何翻山越岭收集超16万菌株?一起探访微生物产业里的硬核“菌”团
翻山越岭,披星戴月,忙于山间田野,不弃只花片叶,他们是慕恩生物一支在前线负责采集微生物样本的队伍。经由他们争分夺秒采集回来的样本,通过分离、培养、筛选、鉴定后,保存至菌种资源库中,成为研发生物农业、生物医药产品的原材料。目前,慕恩生物建立的菌种资源库已从农业土壤、水体、植物和人体中采集、鉴定并保存超过160000株菌株。新菌株的开发为何重要?微生物如何创新应用至农业、医药等领域?高成长企业论调研团本期为你揭晓!
【播出时间】:2022年8月26日下午15:00